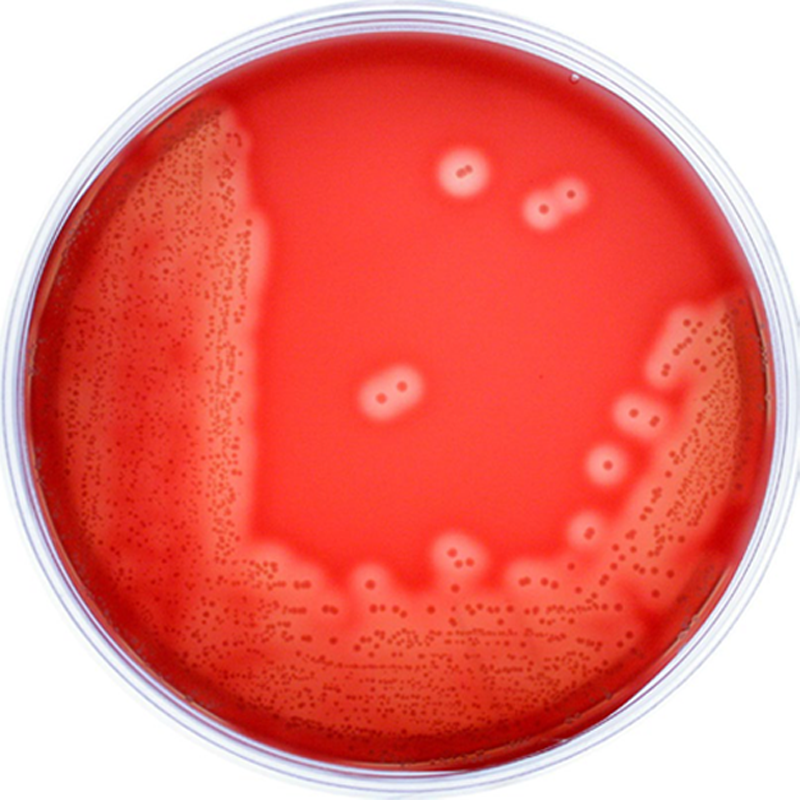

Rapid Test Kits
- HBsAg Test (Serum/Plasma)
Strip / Cassette - HCV Ab Test (Serum/Plasma)
Strip / Cassette - HIV 1/2 Ab Plus Combo Test (Serum/Plasma/Whole Blood)
Strip/Cassette - Syphilis Test (Serum/Plasma)
Strip/Cassette
- Malaria Pf/Pv Antigen Test (Serum/Plasma/Whole Blood)
Cassette - Dengue NS1 Antigen Test (Serum/Plasma/Whole Blood)
Cassette - Dengue IgG/IgM Whole Blood Test (Whole Blood/Serum/Plasma)
Cassette - Duo Dengue IgG/IgM+NS1 Test (Whole Blood/Serum/Plasma)
Cassette
Serology Reagent
- ASO Latex Agglutination Test
- RF/RA Latex Agglutination Test
- CRP Latex Agglutination Test
- Widal Test / Salmonella Antigens
- Anti-A
- Anti-B
- Anti-D IgG+IgM
Clinical Biochemistry Reagent
- Alkaline Phosphate
- Alfa-Amylase MR
- ALAT (GPT)
- ASAT (GOT)
- Bilirubin (Total & Direct)
- Creatinine
- Cholesterol
- HDL-Cholesterol
- Triglycerides (DST)
- Urea (Berthelot Method)
- Uric Acid (DST)